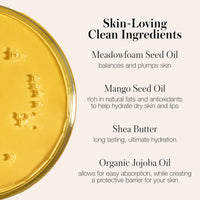

RMS Beauty Go Nude Lip Pencil
$32.00
Define, enhance, and protect your lips with nourishing pigment. A richly pigmented, longwearing, skin-caring creamy lip pencil expertly formulated to complement an inclusive range of nude shades.
With its own sharpener and brush for flawless precision, it glides on easily to naturally define lips, create fullness, and help keep lipstick from feathering or bleeding. It’s easy to apply, goes on perfectly and stays in place. Formulated with a blend of oils and butters, it conditions and softens lips without settling into fine lines.
Includes RMS pencil sharpener.
Key Ingredients:
- Meadowfoam seed oil is a naturally antioxidant-rich and plush emollient that conditions and softens skin and lips
- Extracted from the pit of a mango, mango seed oil is an excellent moisturizer that is rich in natural fats and antioxidants to help hydrate dry skin and lips
- Originating from the seeds of the African karite tree, unrefined organic shea butter is arich moisturizing butter known for long lasting, ultimate hydration
Good To Know:
- 8-hour wear
- Water resistant coverage
- Long-wear pigment
Shade Notes:
- Sunrise Nude: Soft muted pink
- Daytime Nude: Ginger earth
- Morning Dew: Cool dusty rose
- Nighttime Nude: Tawny port
- Sunset Nude: Rich auburn
- Midnight Nude: Deep mahogany
How To Use:
- Draw a line around the lips with the pencil tip
- To enhance your lip size for more impact, draw slightly outside your natural lip line
- Blend with the brush to soften the line, or fill in and use as an all over lipcolor
- Finish with lip color or gloss











